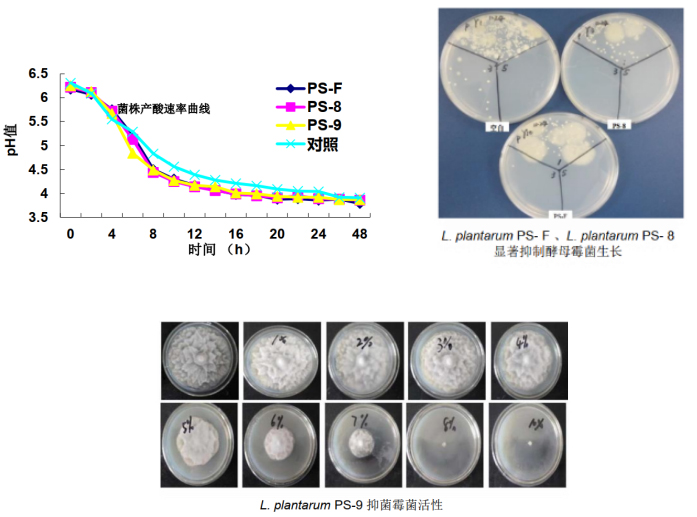
202108253.jpg

在我国很多地区,青饲料的全年平衡供应很难做到,每到冬春季节,如何保证草食家畜的饲料供应就成为养殖业的难题之一。随着养殖业的发展,自然条件下的干草已无法满足饲养需求,青贮已经成为养殖业的普遍选择。
与干草相比,青贮饲料有着显著的优势。青贮过程中饲草的营养损失约为10%,尤其以粗蛋白损失极少,而在自然条件下的干草制作过程中,由于落叶和植物细胞呼吸作用,营养物质损失可达30%。鲜草在干燥过程中,蛋白质、维生素A、类胡萝卜素和维生素E大量损失,尤其以维生素A的损失最高,可达90%以上,相较而言,青贮可有效的保存此类营养物质。研究发现,青贮与干草相比,可提高奶牛产奶量以及乳脂、乳糖和乳蛋白含量。

随着全国各地青贮玉米进入成熟收获时节,青贮饲料的制作也到了关键时期,如何制作出营养成分丰富、适口性好、消化率高的优质青贮饲料也就成为养殖行业重点关注的问题。在最初制作青贮时,并没有青贮发酵剂的存在,只依靠土壤、秸秆本身、空气中的乳酸菌进行发酵。然而,自然条件下的乳酸菌含量较少,使得发酵不足,发酵品质时好时坏;且自然界中含有大量的霉菌,在贮藏时易导致青贮发生霉变,影响贮藏时间;同时产生大量有毒物质,反刍动物采食后易产生腹泻疾病,影响生产性能。因此,随着科学的发展,青贮发酵剂应运而生。
在市面上众多青贮发酵剂中,乳酸菌发酵剂以其独有的优势成为了养殖业的首选。青贮饲料在经过乳酸菌发酵后,质地柔软,具有酸甜清香味,牲畜喜食,可提高动物采食量和消化率。有研究显示,采用益生乳酸菌制作的青贮饲料,经奶牛采食后,可抑制产肠毒素病原菌的生长繁殖,减少奶牛腹泻的发生,还可能在预防和治疗隐性乳房炎以及降低乳体细胞数等方面具有重要作用。
科拓生物作为中国益生菌行业首家上市企业,致力于开发出具有明确菌株来源及发酵特性的青贮专用乳酸菌制剂,科拓生物从20000余株具有自主知识产权的乳酸菌菌种资源库中,通过大量基础研究筛选出多株植物乳杆菌,并对筛选得到的植物乳杆菌进行进一步研究,完成产业化落地,陆续推出反刍动物专用微生态制剂、青贮饲料专用发酵剂、有机物料腐熟剂等系列产品。其中,青贮饲料专用发酵剂已成为众多中大型养殖场的青贮必备好“帮手”。

在产业化的过程中,科拓生物付出了大量的时间和精力来寻找最适合用于工业生产的菌株。为了避免因pH值降低抑制乳酸菌发酵情况的产生,科拓生物通过耐酸试验找到了130株耐酸性能好的菌株;在随后的温度耐受试验中,找出50株在5至50℃时仍保持活性的对温度耐受性强的乳酸菌;为了能够在青贮初期尽快抑制霉菌和酵母菌的生长,减少干物质损失,科拓生物又在50株的基础上,筛选出产酸速率均高于市面上常见乳酸菌的23株菌株;而在接下来的产酸量试验及工艺参数摸索过程中,仅有3株植物乳杆菌通过了筛选,成为可用的乳酸菌菌株。
科拓生物通过严苛的试验和工艺测试,找出了耐酸、耐高温、产酸速率快、产酸量大,且可用于工厂化生产的植物乳杆菌。此3株植物乳杆菌来源清晰,无知识产权风险,功效明确,稳定性较高,适用于青贮发酵,菌种验证信息见下图。
随着科研的深入及市场的拓展,科拓生物结合大量研究成果及市场论证,研发出4款青贮发酵剂,分别为“青贮邦”、“益贮邦”、“鲜贮邦”、“优贮邦”,这4款产品的面市,很快得到了行业内的重点关注,不仅为养殖业带来了更好的青贮专用乳酸菌微生态制剂,还为推动青贮添加剂产业规范,助推行业标准建立方面发挥了重要作用。

科拓生物以其亚洲最大的乳酸菌菌种资源库为依托,以强大的科研实力为助力,筛选出具有自主知识产权且高效稳定的菌株,进而推出以青贮专用乳酸菌微生态制剂为代表的畜牧养殖业系列产品,为中国畜牧养殖业做出应有的贡献。未来,科拓生物将继续秉承“源于自然,传递健康”的理念,为振兴中国畜牧养殖业而努力!